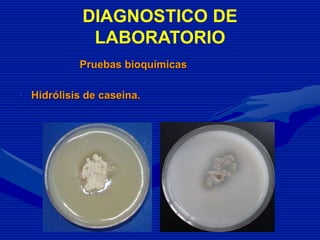
Pruebas bioquímicas
• Hidrólisis de caseina.
DIAGNOSTICO DE
LABORATORIO

Este documento describe el primer caso diagnosticado de actinomicetoma en el Hospital Universitario de Puebla. Se presenta el caso de un hombre de 54 años que desarrolló una lesión en el brazo derecho que evolucionó durante 5 años. Tras realizar diversas pruebas como análisis de sangre, rayos X y biopsia, se diagnosticó actinomicetoma causado por Nocardia asteroides. El paciente fue tratado con amikacina y trimetoprima-sulfametoxazol, lo que detuvo la progresión de la infección.